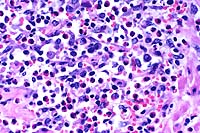

Results
AFIP Wednesday Slide Conference - No. 17
January 20, 1999
- Conference Moderator:
Dr. Jerry L. Quance, Diplomate, ACVP
Maryland Department of Agriculture
Animal Health Laboratory
Frederick, MD 21702.
-
- NOTE: Click on images for larger views. Use
browser's "Back" button to return to this page.
Return to WSC Case Menu
Case I - UCD 2 (AFIP 2648198)
- Signalment: Thirteen-year-old, male, gelded, quarter
horse.
-
- History: The horse was presented with a one week history
of weight loss, drooling, and progressive central nervous system
signs that included a "worried" look, incoordination
with leaning to the left, staggering and disorientation, violent
movements to maintain balance, and episodes of falling down with
eventual recumbency and thrashing movements. In addition, there
was absence of menace response and palpebral reflexes, and suspected
loss of vision on the right side. The horse had been vaccinated
for rabies and tetanus four months previous to the onset of clinical
signs. He was treated with flunixin meglumine, dexamethasone,
and antibiotics, but he continued to decline rapidly over the
following two days and died.
-
- Gross Pathology: Findings included skin lacerations
and contusions from self-trauma and moderate muscle atrophy.
The meninges along the ventral brain stem were congested, and
multifocal, randomly distributed, 4-6 millimeter, brown-gray
foci were present in the ventral midbrain.
-
- Laboratory Results:
1. Clinical chemistry and hematological abnormalities included
elevated direct/indirect bilirubin (0.6/3.6) and slight neutrophilia
with marked lymphopenia.
2. Rabies fluorescent antibody was negative.
3. Sections of brain stem were immunohistochemically positive
for Listeria monocytogenes.
4. Listeria monocytogenes was isolated from sections of brain
stem.
- Contributor's Diagnosis and Comments: Brain stem: Encephalitis,
multifocal, suppurative, acute, severe.
-
- The brain stem contains extensive, multifocal to coalescing
areas of inflammation with multiple microabscesses and variably
thick cuffs of perivascular inflammation. Inflammation extends
into the medulla and cervical spinal cord. Inflammatory infiltrates
are composed of predominately degenerate neutrophils admixed
with fewer macrophages and small amounts of eosinophilic necrotic
tissue debris. Perivascular inflammation contains variable numbers
of neutrophils, lymphocytes, and macrophages. In some vessels,
inflammatory cells appear to be present within and expand the
vascular walls. Mild multifocal hemorrhage is associated with
the inflammation.
-
- The histopathology is compatible with listeriosis, and this
was confirmed both by immunohistochemistry on sections of brain
and isolation of Listeria monocytogenes from frozen brain stem.
Differential diagnosis considered for the gross lesions in the
midbrain was yellow star thistle poisoning, but the histology
consists of coalescing microabscesses, which is more consistent
with listeriosis. A search of the California Veterinary Diagnostic
Laboratory Service case files found only one other diagnosed
case of equine listeriosis, a case of Listeria encephalitis and
septicemia in a five-week-old foal.
 2x
obj
2x
obj 40x
obj
40x
obj
- Case 17-1. Brainstem. Vessels are congested and cuffed
by inflammatory cells. There is multifocal perivascular hemorrhage.
High magnification reveals that perivascular inflammatory cells
are predominantly viable & occassionally degenerate neutrophils
with variable numbers of macrophages and lymphocytes.
 40x
obj, Brown & Brenn Stain
40x
obj, Brown & Brenn Stain
- Case 17-1. Brainstem. Bacilli and coccobacilli are
found with B&B staining.
- AFIP Diagnosis: Brain stem: Encephalitis, subacute,
multifocal, moderate, with microabscesses, hemorrhage, and mild
meningitis, quarter horse, equine.
-
- Conference Note: Listeriosis is caused by a Gram-positive,
facultative anaerobic bacillus that is ubiquitous in the environment
and able to resist harsh environmental conditions. Organisms
can survive in dried media for several months, remain viable
in moist soil for up to ten years, resist high temperature pasteurization
within leukocytes, and can grow at refrigeration temperature.
Until recently, Listeria monocytogenes was the only member of
the genus, but Listeria ivanovii, L. innocua, L. welshimeri,
and L. seeligeri are now separately recognized. Clinical infections
are most commonly caused by L. monocytogenes, though L. ivanovii
is also pathogenic and has been associated with abortion in ruminants.
The other species are considered nonpathogenic.
-
- Listeriosis is a sporadic disease of several animal species
and humans, but is most economically important in ruminants.
Infection with L. monocytogenes is associated with a triad of
clinicopathologic syndromes: most often it causes in encephalitis
in adult animals; it occasionally causes placentitis and abortion
in pregnant animals; and it is an infrequent cause of septicemia
in neonates. Listeriosis is one of the most common causes of
meningitis in humans and nonhuman primates. Listeric septicemia
often results in multifocal hepatic and splenic necrosis, in
addition to central nervous system lesions; neonates generally
become infected in utero. Sporadic cases of listeric septicemia
also occur in domestic fowl, resulting in splenomegaly, hepatic
and myocardial necrosis, and occasional encephalitis. Keratoconjunctivitis
and iritis caused by L. monocytogenes has been reported to occasionally
occur in silage fed cattle and sheep; the condition is usually
unilateral and frequently occurs in winter.
-
- In encephalitic listeriosis, clinical signs reflect lesions
in the brain stem and include dullness, torticollis, circling,
unilateral facial paralysis, and drooling due to pharyngeal paralysis.
Death in sheep and goats may occur in two to three days, while
cattle may survive longer periods. Gross lesions are rarely identified
in the brain, but occasionally the meninges may be thickened
by green gelatinous material, and soft, gray-brown malacic areas
may be present in the brain stem. Characteristic histopathologic
findings in the central nervous system occur most often in the
brain stem and less frequently in the cerebellum and cervical
spinal cord. Microscopic lesions consist of microabscesses in
the neuropil, heavy perivascular infiltrates of lymphocytes,
histiocytes, and occasional neutrophils, acute vasculitis with
fibrin exudation, and meningitis. The ependyma and choroid plexus
are rarely affected.
-
- Several virulence factors for L. monocytogenes have recently
been identified and defined. The organism is capable of surviving
and multiplying within macrophages. The bacterium enters the
host cell, escapes destruction in the phagosome, multiplies within
the cytoplasm, and spreads to other cells. The ability of the
organism to lyse the phagosomal membrane through secretion of
hemolysin and listeriolysin and escape into the cytoplasm is
a key virulence factor. Another virulence factor is the ability
of the organism to move within the cytoplasm; this is mediated
by a bacterial surface protein that causes polymerization of
host cell actin filaments and propels the organism into neighboring
cells. Several other virulence factors are discussed in a recent
review article of listeriosis cited in the references. While
virulence factors have been well-characterized, the exact route
of infection in the encephalitic form of the disease remains
to be determined. Experimental studies have not conclusively
determined the pathogenesis of listeric encephalitis, and hematogenous
routes as well as centripetal passage of bacteria by way of cranial
nerves remain possible mechanisms of central nervous system infection.
-
- Contributor: California Veterinary Diagnostic Laboratory
Services, School of Veterinary Medicine, Univ. of California
Davis, PO Box 1770, Davis, CA 95617.
-
- References:
- 1. Marco A, et al.: Immunocytochemical detection of Listeria
monocytogenes in tissue with the peroxidase-antiperoxidase technique.
Vet Pathol 25:385-387, 1988.
- 2. Weinstock D, Horton SB, Rowland PH: Rapid diagnosis of
Listeria monocytogenes by immunohistochemistry in formalin-fixed
brain tissue. Vet Pathol 32:193-195, 1995.
- 3. Wallace S, Hathcock T: Listeria monocytogenes septicemia
in a foal. J Amer Vet Med Assoc 207:1325-1326.
- 4. Low JC, Donachie W: A review of Listeria monocytogenes
and listeriosis. The Veterinary Journal 153:9-29, 1997.
-
Case II - 1953-98 (AFIP 2643248)
- Signalment: One-year-old, male, breed unspecified,
cat.
-
- History: The cat presented with generalized icterus
following castration. The animal bled profusely after castration
and developed an atonic bladder.
-
- Gross Pathology: A limited autopsy was performed by
the submitting veterinarian. The urinary bladder was described
as "inflamed". The kidney and liver were diffusely
mottled.
-
- Laboratory Results: None available.
-
- Contributor's Diagnoses and Comments:
- 1. Urocystitis, necro-ulcerative, pyogranulomatous, transmural,
diffuse, due to invasive Candida albicans infection.
- 2. Tubulointerstitial nephritis, granulomatous, multifocal
with intralesional yeast and pseudohyphae of Candida albicans.
-
- Pathologic alterations are limited to the urinary system.
The kidneys are bilaterally involved. Brain, spinal cord, and
thoracic organs are not available for histopathologic examination.
Ascending infection via the ureter is the most likely source
of dissemination to the kidney, yet inflammation in the renal
pelvis is minimal. Clinically, feline candidiasis is generally
associated with immunosuppression. Panleukopenia virus, feline
immunodeficiency virus, and feline leukemia virus status in this
cat are unknown. Information about emperic treatment, such as
antibiotic or glucocorticoid therapy, the presence of an indwelling
transurethral catheter, and aciduria may substantiate an immunosuppressive
state and help to differentiate acquired predisposing risk factors
from inate immunodeficiency conditions and underlying viral infections.
Amelioration of risk factors has been associated with spontaneous
resolution of funguria in cats. Alkalization of urine and administration
of antifungal chemotherapy are needed to control disease.
-
- Production of adhesins, proteases, and capsules contributes
to the virulence of fungal infections such as Aspergillus fumigatus,
Candida albicans, and Cryptococcus neoformans. In mice, there
is evidence of two independent host genes influencing the severity
of tissue damage and susceptibility to pyelonephritis in the
murine model of systemic candidiasis. It has been shown that
host defenses against candidiasis are impaired in intracellular
adhesion molecule-1 deficient mice due to impaired neutrophil
migration, impaired phagocyte activation, or both.
 4x
obj
4x
obj 40x
obj
40x
obj
- Case 17-2. Urinary bladder. Hemorrhage, thrombosis
and inflammatory cells replace urothelium and infiltrate underlying
smooth muscle. Vessel walls are multifocally replaced by necrotic
debris, neutrophils, macrophages and fungal hyphae. Some vessels
contain fibrin thrombi.
 40x
obj
40x
obj 40x
obj, PAS
40x
obj, PAS
- Case 17-2. Kidney. Multifocally, tubular epithelium
is necrotic and replaced by abundant fungal hypha and pseudohyphae
admixed with neutrophils and fewer macrophages. PAS staining
illustrates the branching nature of hyphae and the segmentation
of pseudohyphae.
 20x
obj
20x
obj
- Case 17-2. Kidney. Scattered venous thrombosis is
accompanied by pyogranulomatous inflammation replacing vascular
walls and extending into the interstitium.
- AFIP Diagnoses:
- 1. Urinary bladder: Cystitis, ulcerative, pyogranulomatous,
diffuse, severe, with necrotizing vasculitis, and many hyphae,
pseudohyphae, and yeasts, breed unspecified, feline.
2. Kidney: Nephritis, tubulo-interstitial, pyogranulomatous,
multifocal, moderate, with vasculitis, fibrin thrombi, and few
yeasts.
-
- Conference Note: The mucosa of the urinary bladder
is diffusely ulcerated and replaced by a coagulum of hemorrhage,
fibrin, edema, high numbers of viable and degenerate neutrophils
and macrophages, fewer lymphocytes, and many yeasts. Similar
inflammatory cells and yeasts transmurally infiltrate and expand
the remainder of the urinary bladder, and there is extensive
necrosis of smooth muscle and vessels. Histochemical stains submitted
by the contributor, including the Grocott's methenamine silver
method counterstained with hematoxylin and eosin and the periodic
acid-Schiff reaction, demonstrate many fungal pseudohyphae, septate
hyphae, and blastoconidia. A few fungal structures are found
within degenerate and necrotic vessels. Morphologically, pseudohyphae
are seen as chains of yeastlike cells which remain attached end
to end and have prominent constrictions at points of attachment.
True hyphae are tubular and have parallel cell walls with no
constrictions. Blastoconidia are thick-walled, spherical structures
which measure between 8 to 12mm in diameter.
-
- Multifocally, the interstitium of the renal cortex is infiltrated
and expanded by moderate numbers of viable and degenerate neutrophils
and macrophages, and fewer lymphocytes and plasma cells. Inflammatory
infiltrates are oriented around both cortical tubules and vessels;
inflammatory cells often infiltrate and expand vessel walls and
disrupt the endothelium. Significantly fewer inflammatory cells
infiltrate the renal medulla. Examination of special stains reveals
radially oriented hyphae and pseudohyphae that fill and disrupt
a few subcapsular tubules. Focally, one or two medullary tubules
also contain a few fungal hyphae. Organisms were not found within
inflamed vessels.
-
- Like the contributor, participants found it difficult to
determine the route of fungal dissemination to the kidney. The
presence of yeasts within renal tubules, albeit infrequent, suggests
an ascending route of renal infection. Hematogenous dissemination
of fungi to the kidney was considered by participants due to
the vascular lesions and inflammatory cells surrounding vessels,
although yeasts were not found within vessel walls or lumens.
Additionally, participants considered concurrent infection with
the noneffusive form of feline infectious peritonitis (FIP) virus
as the cause of pyogranulomatous inflammation multifocally surrounding
and disrupting renal cortical vessels. The contributor discusses
the potential for underlying viral infection in this cat, and
notes several prediposing factors associated with feline candidiasis
including various causes of immunosuppression. The history, signalment,
and description of clinical signs provided by the contributor
are also suggestive of FIP. Approximately 50% of cats with FIP
are young (2 years or less), and may have a history of recent
stress. In the noneffusive form, multiple organ systems may be
affected, including the liver, and hepatic insufficiency and
icterus may occur. The stress of castration may have triggered
the development of both renal candidiasis and noneffusive FIP.
It is unfortunate that other tissues were not available for microscopic
examination.
-
- Contributor: C. E. Kord Animal Disease Diagnostic
Laboratory, P.O. Box 40627, Melrose Station, Nashville, TN 37204.
-
- References:
- 1. Davies C, Troy GC: Deep mycotic infections in cats. J
Amer Anim Hosp Assoc 32:380-391, 1996.
- 2. Ashman RB, et al.: Evidence that two independent host
genes influence the severity of tissue damage and susceptibility
to acute pyelonephritis in murine systemic candidiasis. Microbial
Pathogenesis 22:187-192, 1997.
- 3. Lulich JB, Osborne CA: Fungal infections of the feline
lower urinary tract. Vet Clin N Amer Small Anim Pract 26:309-315,
1996.
- 4. Davis SL, et al.: Host defenses against host disseminated
candidiasis are impaired in intracellular adhesion molecule-1
deficient mice. J Infect Dis 174: 435.
- 5. Jones TC, Hunt RD, King NW: Diseases caused by viruses.
In: Veterinary Pathology, 6th ed., pp. 352-353, Williams and
Wilkins, Baltimore, 1997.
- 6. Greene CE, Chandler FW: Candidiasis, torulopsosis, and
rhodotorulosis. In: Infectious Diseases of the Dog and Cat, Greene
CE, ed., 2nd ed., pp. 414-417, WB Saunders Co., Philadelphia,
1998.
-
Case III - 17680-98 (AFIP 2641600)
- Signalment: Six-week-old, crossbred, domestic pig.
History: Three to four weeks post-weaning, pigs became
unthrifty. Clinical signs included fever and dyspnea.
- Gross Pathology: There were moderate numbers of loose
fibrin strands in the peritoneal and thoracic cavities. Lungs
were diffusely dark red and contained dark purple accentuated
lobules. The liver was enlarged, and a marked amount of blood
exuded from its cut surface. The contents of the small and large
intestines had a semifluid consistency.
-
- Laboratory Results: Salmonella cholerasuis var. kunzendorf
was isolated from a composite of lung and liver.
-
- Contributor's Diagnosis and Comments: Severe subacute
multifocal, histiocytic and neutrophilic hepatitis with necrosis,
Salmonella cholerasuis var. kunzendorf.
-
- The liver is characterized by severe multifocal hepatocellular
necrosis. The necrotic foci vary in appearance. Many necrotic
foci are characterized by coagulation necrosis with hemorrhage,
while other foci contain histiocytes and degenerate neutrophils
or a mixed mononuclear cell infiltrate consisting of histiocytes
and occasional lymphocytes and plasma cells. Fibrin thrombi can
be seen in periportal veins and in sinusoids. Moderate to high
numbers of mixed mononuclear inflammatory cells infiltrate periportal
areas.
-
- The lesions that occurred are caused by endothelial damage
by endotoxin and localization of organisms within affected tissues.
Salmonellosis is a major concern to veterinarians and pork producers
as a cause of septicemia and diarrhea in pigs. Some species of
salmonella are a major concern as food-borne pathogens for humans.
 10x
obj
10x
obj
- Case 17-3. Liver. Multifocally there are small foci
of necrosis containing cell debris, and variable numbers of neutrophils
and macrophages (paratyphoid nodules).
- AFIP Diagnosis: Liver: Hepatitis, random, necrotizing,
acute, multifocal, moderate, with fibrin thrombi, crossbreed
domestic pig, porcine.
-
- Conference Note: Salmonella are members of the family
Enterobacteriaceae and are primarily associated with self-limiting
enteric disease, although they cause systemic, life-threatening
illness in some cases. The organisms are non-sporulating, Gram-negative,
bacilli which measure 2-5mm in length and 0.7-1.5mm in width.
The bacteria move by means of peritrichous flagella. Currently,
the various salmonellae are classified as a single species known
as Salmonella enterica. Many serovars of S. enterica are known
to exist, and substitution of the serovar name for the species
is common. The classic form of salmonellosis in humans is known
as typhoid fever and is caused by S. typhi. Some species of Salmonella
are host specific, such as S. typhi in humans and S. cholerasuis
in swine. Other species (serovars) of the genus, such as S. typhimurium,
infect a wide range of animals causing gastroenteritis, occasionally
leading to septicemia. The disease is most frequent in cattle,
horses, and swine, and is uncommon in dogs and cats. Reptiles
may be subclinical carriers of the organism and serve as a source
of zoonotic infection to humans.
-
- Infection is acquired by ingestion of bacteria. Bacteria
that survive passage through the stomach invade intestinal epithelial
cells at villar tips. Invasion genes induced by low oxygen tension
in the intestine control entrance of bacteria into enterocytes.
These genes encode proteins associated with adhesion of the organism
and recruitment of host cell cytoskeletal proteins, causing internalization
of the bacterium. Invasion of the mucosa, injury to enterocytes,
host inflammatory response, and sloughing of enterocytes cause
gastroenteritis and diarrhea. Some salmonella may elaborate heat-labile
enterotoxins that increase adenyl cyclase in enterocytes and
stimulate secretion of fluid by the intestinal mucosa, exacerbating
diarrhea and fluid loss. After penetrating the epithelium, the
bacteria enter the lamina propria and proliferate within the
interstitium and within tissue macrophages.
-
- Enteric infection is followed by clinical resolution in most
cases, but occasionally bacteremia and endotoxemia develop, especially
in young animals. Septicemia occurs when bacteria are transported
by macrophages to the mesenteric lymph nodes. The bacteria may
spread to many tissues, including joints, spleen, liver, brain,
and meninges. Endotoxemia results from the lipopolysaccharide
in bacterial cell walls. Lipopolysaccharide induces vascular
dilatation, pooling and activation of platelets and leukocytes,
hypoglycemia, complement activation, and release of vasoactive
amines. Disseminated intravascular coagulation is a common sequela
to endotoxemia. Abortions and stillbirths may occur as a result
of acute enteritis or septicemia in infected pregnant animals.
Chronic carriers may develop as a result of persistently infected
phagocytic cells in the liver, spleen, and mesenteric lymph nodes.
Shedding of bacteria or reactivation of disease may occur during
periods of stress, immunosuppression, or due to other systemic
infections.
-
- Contributor: Veterinary Diagnostic Center, Fair Street
and East Campus Loop, Lincoln, NE 68583-0907.
-
- References:
- 1. Barker IK, Van Dreumel AA, Palmer N: The alimentary system.
In: Pathology of Domestic Animals, Jubb KVF, Kennedy PC, Palmer
N, eds., 4th ed., vol. 2, pp. 213-221, Academic Press, San Diego,
CA, 1993.
- 2. Wilcock BP, Schwartz KJ: Salmonellosis. In: Diseases of
Swine, Leman AD, et al., eds., 7th edition, pp. 570-583, Iowa
State University Press, Ames, Iowa, 1992.
- 3. Lawson GHK, Dow C: Porcine salmonellosis: A study of the
field disease. J Comp Path 76:363-371, 1966.
- 4. Jones TC, Hunt RD, King NW: Diseases caused by bacteria.
In: Veterinary Pathology, 6th ed., pp. 453-455, Williams and
Wilkins, Baltimore, MD, 1997.
- 5. Greene CE: Salmonellosis. In: Infectious Diseases of the
Dog and Cat, Greene CE, ed., 2nd edition, pp. 235-240, WB Saunders
Co., Philadelphia, PA, 1998.
- 6. Cotran RS, Kumar V, Collins T: Infectious diseases. In:
Robbins Pathologic Basis of Disease, 6th ed., pp. 356-357, WB
Saunders, Philadelphia, PA, 1999.
-
Case IV - 98-1045 (AFIP 2641073)
- Signalment: Four-year-old, lactating, Holstein cow.
-
- History: Over a six week period, ten cows from the
lactating herd died. They were noted down in milk production
at one milking and found dead at the next milking. Two other
cows, including this cow, survived several days with non-specific
clinical signs and were euthanatized. This cow had decreased
milk production and weight loss.
-
- Gross Pathology: Necropsy findings included generalized
lymphadenopathy, enlarged kidneys with radial white streaking
in the cortex, white streaks in the heart, and enlarged adrenal
glands with obliteration of the architecture. The liver had focal
areas of fibrosis centered around portal vessels.
-
- Laboratory Results: Anemia, lymphocytosis, thrombocytopenia,
azotemia, elevated creatinine, hypocalcemia, and hyperphosphatemia
were present.
-
- Contributor's Diagnoses and Comments: Lymphogranulomatous
myocarditis, splenitis, hepatitis, and interstitial nephritis.
-
- Liver, spleen, heart, and kidneys had lymphocytic to lymphogranulomatous
inflammation which destroyed much of the parenchyma in those
organs. The adrenal glands were obliterated by the inflammation.
Eosinophils are numerous in some lesions. The liver also has
phlebitis of the portal veins which may not be present in all
slides submitted.
-
- The lesions are similar to those seen in hairy vetch toxicity
of cattle, and suggest a type 4 hypersensitivity reaction. No
vetch was being fed to these animals, but six weeks prior to
the first death citrus pulp was added to the diet. There are
several reports of similar disease and pathology in cattle associated
with the feeding of citrus pulp. In those reports, the kidneys
and heart were most often affected, but multiple organs were
usually affected. The severity of disease and organs involved
were quite variable. Such was the case in this group of cows.
A hemorrhagic syndrome affecting serosal surfaces has been reported
in some cases, and this was seen in several of the cows of this
outbreak. Vasculitis has been reported in some cases with the
hemorrhagic syndrome. Vasculitis was seen in this cow and in
another animal, but only in the liver, and was not associated
with hemorrhage.
-
- Citrus pulp was fed to the lactating and near term cows in
this herd, but the lactating cows received twice the amount of
citrus pulp. No disease occurred in the near term cows. Citrus
pulp contains several plant lectins, and it is suspected that
one of these induces a type 4 hypersensitivity reaction that
accounts for the inflammatory reaction seen. Citrus pulp is commonly
fed to cattle without causing problems, so there must be other
factors involved in the initiation of this disease.

- Case 17-4. Kidney. Multifocally expanding the interstitium
and replacing selected tubules there is a dense infiltrate of
lymphocytes, plasma cells and fewer macrophages.
 10x
obj
10x
obj 10x
obj
10x
obj
- Case 17-4. Heart, pericardial fat. Expanding the myocardial
interstitium and extending into the pericardial fat there are
similar infiltrates of lymphocytes, plasma cells, macrophages,
fibroblasts, and occasional foreign body giant cells.
 4x
obj
4x
obj  40x
obj
40x
obj
- Case 17-4. Spleen. The white pulp is expanded by similar
infiltrates of cells rare foreign body and Langhans giant cells.
 10x
obj
10x
obj 40x
obj
40x
obj
- Case 17-4. Liver. Hepatic parenchyma is expanded and
replaced by high numbers of eosinophils, lymphocytes, macrophages,
and fibroblasts.
-
- AFIP Diagnoses:
- 1. Kidney: Nephritis, interstitial, granulomatous and eosinophilic,
multifocal, moderate, Holstein, bovine.
2. Heart: Myocarditis and epicarditis, granulomatous and eosinophilic,
multifocal, moderate, with myofiber degeneration, necrosis, and
loss, and pericardial steatitis.
3. Spleen: Splenitis, nodular, granulomatous and eosinophilic,
multifocal to coalescing, moderate.
4. Liver: Hepatitis, portal and periportal, lymphohistiocytic
and eosinophilic, diffuse, moderate, with portal phlebitis and
mild biliary hyperplasia.
-
- Note: Numbers of eosinophils and multinucleate giant
cells vary within organs and in areas examined. Some sections
of heart contain sarcocysts.
-
- Conference Note: A syndrome of pyrexia, dermatitis,
and hemorrhage with similarities to hairy vetch toxicity has
been reported in dairy cows in several countries, including the
United States, England, Wales, France and the Netherlands. Affected
animals present with a wide variety of clinical and pathological
syndromes, including pruritic and papular eruptions of the head,
neck, tailhead, and udder, mononuclear and eosinophilic inflammatory
infiltrates with multinucleate giant cells in various organs,
and hemorrhage.
-
- The cause of the disease is uncertain, but several etiologies
have been proposed including mycotoxin T2, ochratoxin A, citrinin,
di-ureido-isobutane (DUIB) feed additive, sweet vernal hay containing
dicoumarol, and introduction of new silage to the herd. Despite
the uncertainty of the inciting agent(s), most reports describe
similar histopathological features that include varying infiltrates
of lymphocytes, macrophages, multinucleate giant cells and eosinophils
with multifocal granulomas in a variety of organs, including
the kidneys, heart, liver, spleen, adrenal glands, and lymph
nodes; vasculitis and thromboses are occasionally reported. These
microscopic findings seem to represent a common inflammatory
response to a variety of related causes. This condition of dairy
cows has similar pathological features to idiopathic eosinophilic
dermatitis of the horse.
-
- The contributor notes that, in addition to plant lectins,
other factors are likely involved in the initiation of disease
in dairy cows. In an outbreak of pruritus, pyrexia, and hemorrhagic
syndrome of cows in England, clinical signs occurred in some
animals within three days of starting a new feed containing citrus
pulp, and several within the herd died over a course of one month
while on the ration. In this case, the citrus pulp was found
to be moldy, and the mycotoxin citrinin was identified in the
feed and implicated as the cause of the disease.
-
- Contributor: Department of Biomedical Sciences and
Pathobiology, College of Veterinary Medicine, Virginia Tech,
Blacksburg, VA 24061-0442.
-
- References:
- 1. Griffiths B, Done SH: Citrinin as a possible cause of
the pruritus pyrexia, and hemorrhagic syndrome of cattle. Vet
Record 129:113-117, 1991.
- 2. Panciera RJ: Hairy vetch (Vicia villosa roth) poisoning
in cattle. In: Effects of Poisonous Plants on Livestock, Keeler
RJ, James LF, eds., pp. 555-563, Academic Press, New York, 1978.
- 3. Yager JA, Scott DW: The skin and appendages. In: Pathology
of Domestic Animals, Jubb KVF, Kennedy PC, Palmer N, eds., 4th
ed., vol. 1, pp. 591-592, Academic Press, San Diego, CA, 1993.
-
- Ed Stevens, DVM
Captain, United States Army
Registry of Veterinary Pathology*
Department of Veterinary Pathology
Armed Forces Institute of Pathology
(202)782-2615; DSN: 662-2615
Internet: STEVENSE@afip.osd.mil
-
- * The American Veterinary Medical Association and the American
College of Veterinary Pathologists are co-sponsors of the Registry
of Veterinary Pathology. The C.L. Davis Foundation also provides
substantial support for the Registry.
- Return to WSC Case Menu
 2x
obj
2x
obj 40x
obj
40x
obj
 40x
obj, Brown & Brenn Stain
40x
obj, Brown & Brenn Stain
 4x
obj
4x
obj 40x
obj
40x
obj
 40x
obj
40x
obj 40x
obj, PAS
40x
obj, PAS
 20x
obj
20x
obj
 10x
obj
10x
obj

 10x
obj
10x
obj 10x
obj
10x
obj
 4x
obj
4x
obj  40x
obj
40x
obj
 10x
obj
10x
obj 40x
obj
40x
obj